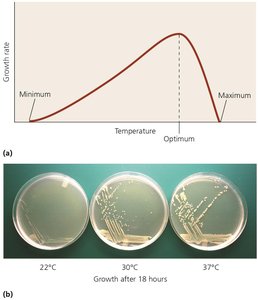
Effects of temperature on microbial growth
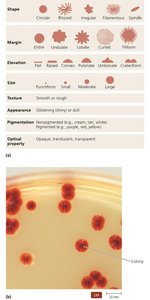
Characteristics of bacterial colonies
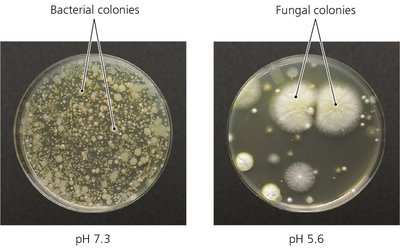
Selective medium example
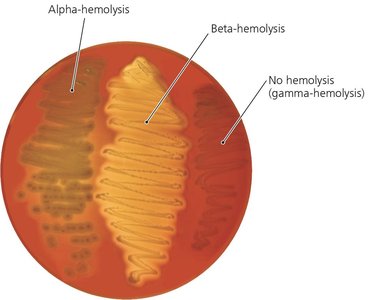
Blood agar as a differential medium
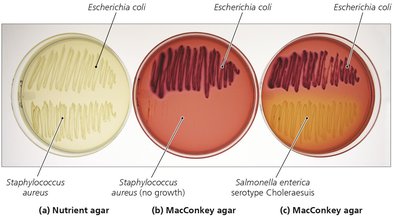
MacConkey agar as selective and differential medium

Back
BackMicrobial Nutrition and Growth: Study Notes
Study Guide - Smart Notes

Microbial Nutrition and Growth
Introduction to Microbial Growth
Microbial growth refers to the increase in the number of microorganisms in a population, primarily through the reproduction of individual cells. This process results in the formation of discrete colonies or complex communities known as biofilms.
Colony: An aggregation of cells arising from a single parent cell.
Biofilm: A collection of microbes living on a surface in a complex community.
Growth Requirements
Chemical and Energy Requirements
Microorganisms require various nutrients for energy and to build cellular structures. The most common elements needed are carbon, oxygen, nitrogen, and hydrogen. Microbes are classified based on their sources of carbon, energy, and electrons.
Autotrophs: Use carbon dioxide as a carbon source.
Heterotrophs: Use organic compounds as a carbon source.
Phototrophs: Obtain energy from light.
Chemotrophs: Obtain energy from chemical compounds.
Organotrophs: Obtain electrons from organic molecules.
Lithotrophs: Obtain electrons from inorganic molecules.

Oxygen Requirements
Oxygen is essential for some organisms but toxic to others due to the formation of reactive oxygen species. Microbes are classified by their oxygen requirements:
Obligate aerobes: Require oxygen for growth.
Obligate anaerobes: Oxygen is toxic; they cannot survive in its presence.
Facultative anaerobes: Can grow with or without oxygen but grow better with it.
Aerotolerant anaerobes: Do not use oxygen but can tolerate its presence.
Microaerophiles: Require low levels of oxygen.

Nitrogen, Phosphorus, Sulfur, and Growth Factors
Nitrogen is essential for the synthesis of amino acids and nucleotides. Some bacteria can fix atmospheric nitrogen. Other elements like phosphorus and sulfur are also required, along with trace elements and growth factors (organic molecules that some organisms cannot synthesize).
Growth Factor | Function |
|---|---|
Amino acids | Components of proteins |
Cholesterol | Used by mycoplasmas for cell membranes |
Heme | Functional portion of cytochromes in electron transport |
NADH | Electron carrier |
Niacin (vitamin B3) | Precursor of NAD+ and NADP+ |
PABA | Precursor of folic acid, involved in nucleic acid synthesis |
Physical Requirements for Growth
Temperature
Temperature affects protein structure and membrane fluidity. Microbes are classified by their preferred temperature ranges:
Psychrophiles: Grow best at low temperatures (below 20°C).
Mesophiles: Grow best at moderate temperatures (20–45°C).
Thermophiles: Grow best at high temperatures (above 45°C).
Hyperthermophiles: Grow best at extremely high temperatures (above 80°C).

pH
Microorganisms are sensitive to pH changes, which affect hydrogen bonding in proteins and nucleic acids.
Neutrophiles: Grow best at neutral pH (around 7).
Acidophiles: Grow best in acidic environments.
Alkalinophiles: Grow best in alkaline environments.
Water, Osmotic Pressure, and Hydrostatic Pressure
Water is essential for microbial metabolism. Osmotic pressure affects cell water balance, while hydrostatic pressure is important for barophiles (organisms living under high pressure).
Obligate halophiles: Require high salt concentrations.
Facultative halophiles: Can tolerate high salt but do not require it.
Barophiles: Thrive under high hydrostatic pressure.
Microbial Associations and Biofilms
Types of Relationships
Microorganisms can interact in various ways:
Antagonistic: One organism harms another.
Synergistic: Both benefit, but the relationship is not essential.
Symbiotic: Both benefit and the relationship is essential for survival.
Biofilms
Biofilms are complex communities of microorganisms attached to surfaces and embedded in a self-produced extracellular matrix. They form through a process called quorum sensing, where microbes communicate and coordinate behavior based on cell density. Biofilms are common on medical devices and mucous membranes and are often more resistant to antibiotics.


Culturing Microorganisms
Obtaining Pure Cultures
Pure cultures are obtained to study a single microbial species. The most common isolation techniques are the streak plate and pour plate methods. Aseptic technique is essential to prevent contamination.

Culture Media
Microbes are grown on various types of media, which can be liquid (broth) or solid (agar). Media types include:
Defined (synthetic) media: Exact chemical composition is known.
Complex media: Contains nutrients from extracts; composition is not precisely known.
Selective media: Favors or inhibits the growth of certain microbes.
Differential media: Distinguishes microbes based on metabolic reactions.
Anaerobic media: Supports growth of anaerobes.
Transport media: Used to transport clinical specimens safely.

Growth of Microbial Populations
Binary Fission and Generation Time
Most bacteria reproduce by binary fission, a process in which one cell divides into two identical daughter cells. The generation time is the time required for a cell to divide and is influenced by environmental conditions.

Population Growth Curves
Bacterial populations typically exhibit four phases of growth:
Lag phase: Cells adjust to their environment; little to no division.
Log (exponential) phase: Rapid cell division and population growth.
Stationary phase: Growth rate slows as resources become limited.
Death (decline) phase: Cells die faster than new cells are produced.




Continuous Culture
A chemostat is used to maintain microbial populations in a specific phase of growth by continuously adding fresh medium and removing old medium. This is important in industrial microbiology.

Measuring Microbial Growth
Direct Methods
Microscopic counts: Counting cells under a microscope.
Electronic counters: Coulter counter and flow cytometry.
Serial dilution and viable plate counts: Estimating population size by counting colonies.
Membrane filtration: Used for small populations.
Most probable number (MPN): Statistical estimation based on dilution series.




Indirect Methods
Turbidity: Measuring cloudiness of a culture using a spectrophotometer.
Metabolic activity: Measuring products of metabolism.
Dry weight: Weighing biomass after drying.
Molecular methods: Detecting DNA sequences of unculturable microbes.

Case Study: Listeria monocytogenes
Listeria monocytogenes is a bacterium that can survive in diverse environmental conditions and cause central nervous system infections, especially in immunocompromised individuals. It can be identified using selective and differential media, and some antibiotics used to treat listeriosis inhibit bacterial enzymes.
Summary: Understanding microbial nutrition and growth is essential for culturing, identifying, and controlling microorganisms in clinical, industrial, and environmental settings.
